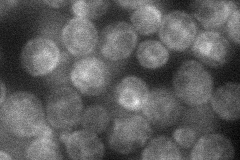
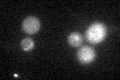

View description
Voltage-gated high-affinity calcium channel involved in calcium influx in response to some environmental stresses as well as exposure to mating pheromones; interacts and co-localizes with Mid1p, suggesting Cch1p and Mid1p function together
Localization:
Intensity:
Fold change:
Significance:
-
C’ GFP library in SD

below threshold17.8 -
N' NOP1pr-GFP in SD

ER35.7765 -
N' TEF2pr-mCherry in SD
ER32.9021 -
N' NATIVEpr-GFP in SD

below threshold23.8381 -
N' TEF2pr-VC and Cyto-VN in SD

below threshold33.5669 -
C’ GFP library in SD+DTT
cytosol20.571.15No -
C’ GFP library in SD+H2O2

cytosol19.781.11No -
C’ GFP library in Starvation Media

cytosol17.981.01No -
C’ GFP library on the background of Pup2-DaMP

below threshold -
C’ GFP library on the background of CCT mutant

below threshold15.48250.869551No
